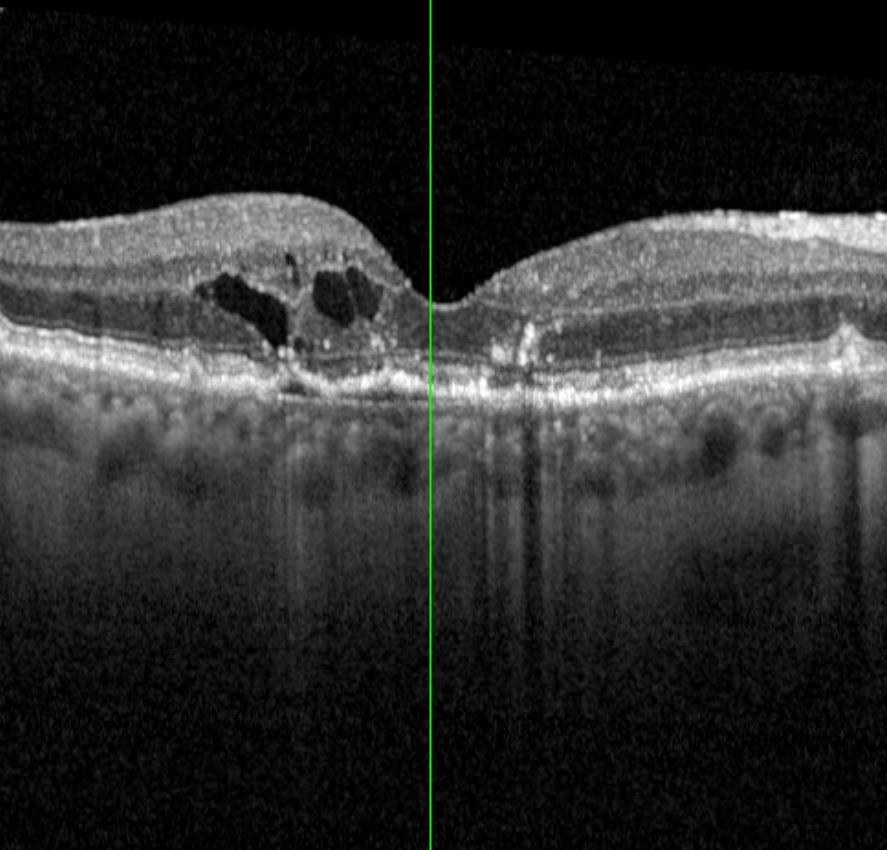
Augenklinik Castrop-Rauxel IVOM

IVOM
Wir behandeln Ihre Netzhauterkrankung
Netzhauterkrankungen
Es gibt viele unterschiedliche Netzhauterkrankungen, welche sich mit diversen Symptomen äußern. Hierzu zählen zB die epiretinale Gliose, Thrombosen, diabetische Veränderungen, Maculaforamen oder Netzhautablösungen.
Die häufigste Erkrankung ist die so genannte altersbedingte Maculadegeneration. Hier unterscheidet man die trockene und feuchte Form.
Durch modernste Techniken haben wir die Möglichkeit Ihre Netzhaut zu untersuchen. Sollte bei Ihnen ein chirurgischer Eingriff (pars plana Vitrektomie) oder eine Therapie mit intravitrealer Medikamenteneingabe (IVOM) nötig sein, so können wir dies in unserer Klinik durchführen.

Augenärztliche Gemeinschaftspraxis
Münsterplatz 6
44575 Castrop-Rauxel
Augen- & Laserklinik Castrop Rauxel GmbH
Münsterplatz 7
44575 Castrop-Rauxel
Privatpraxis Henrichenburg
Lambertstr. 6
44581 Castrop-Rauxel
Kontakt
Augen- & Laserklinik Castrop-Rauxel
- +49 (0) 23 05 / 921 200
- +49 (0) 23 05 / 47 72
- info@augenklinik-castrop-rauxel.de
OP-Termine
- +49 (0) 23 05 / 921 20 35
Privatpraxis Henrichenburg
- +49 (0) 23 67 / 181 990
Weitere Links
© 2021 Augen- & Laserkinik Castrop Rauxel GmbH | Developed by: AGit-Consulting Arthur Gorski